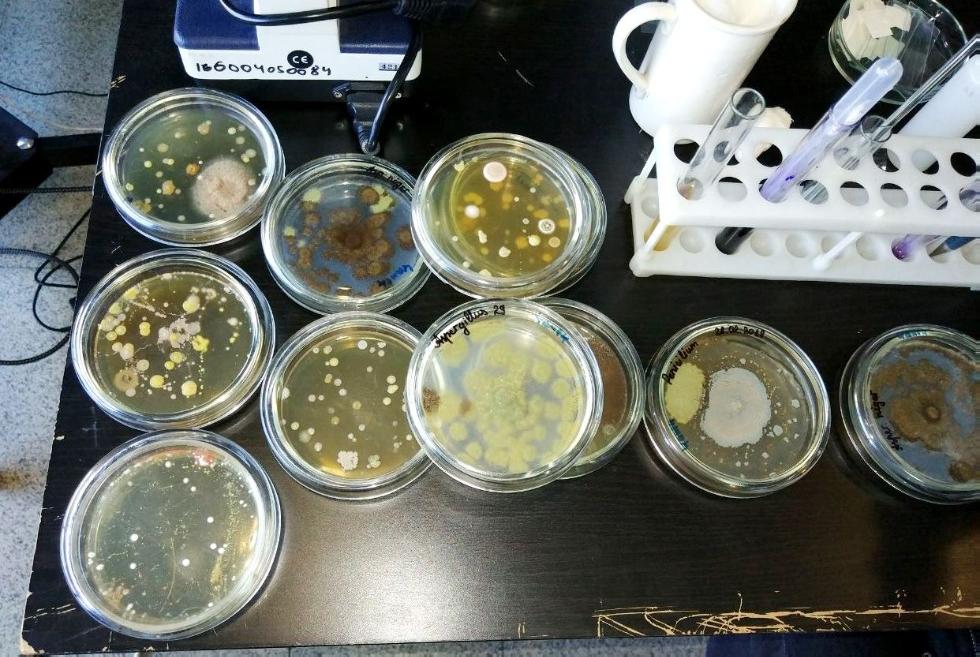
� ��� ������ ���� ����������� � �������� ��������������� �������� ���

Казанский федеральный университет принял слет победителей и призеров межрегиональных олимпиад КФУ. У участников слета была возможность познакомиться с профильными институтами и преподавателями.
Стартовало мероприятие в КСК КФУ УНИКС, там для школьников были подготовлены интерактивы - Институт фундаментальной медицины и биологии представил для ребят мастер-класс "Привет, микромир", где у всех желающих была возможность поработать с микроскопом и увидеть результат на плазменном мониторе.
Основная встреча слета прошла там же. Школьников, их классных руководителей и родителей приветствовал первый проректор Казанского федерального университета Рияз Минзарипов.
«Мы рады встрече с вами. Надеемся, что, победив в олимпиадах, вы приобретете определенный статус и уважение среди студенческой и научной общественности. Также надеемся, что ваш путь будет проложен в сторону Казанского федерального университета, - отметил первый проректор КФУ. – За победу в олимпиадах у нас предусмотрены определенные преференции».
К слову о преференциях: при поступлении в КФУ вуз действительно добавляет 5 баллов к полученным результатам ЕГЭ.
В своей речи Рияз Минзарипов призвал обратить внимание на созданные в КФУ условия для обучения, а также творческой реализации.
«Я без прикрас скажу, что условия прекрасные. Поэтому у вас будут все возможности, чтобы стать учеными, профессионалами, - резюмировал он. – Помните, что, окончив Казанский федеральный университет, вы приобретете диплом одного из уважаемых вузов, который котируется за рубежом. В добрый путь!»
Далее начальник отдела организации культурно-массовой и организационной работы Департамента по молодежной политике, социальным вопросам и развитию системы физкультурно-спортивного воспитания КФУ Регина Халикова представила гостям презентацию общественных студенческих организаций и объединений университета. В рамках презентации школьники узнали о деятельности, задачах, целях и основных мероприятиях наиболее значимых студенческих общественных организаций и объединений.
«Вот уже 13-й год КФУ проводит межрегиональные предметные олимпиады. В этом году впервые мы провели олимпиады по 20 предметам, у нас появились новые направления, - поделилась в интервью Единому информационно-издательскому центру КФУ директор Центра по работе с одаренными школьниками Департамента образования КФУ Диляра Муравьева. – Межрегиональные предметные олимпиады проходят в два тура: интернет-тур, участие в котором в этом году приняли более 23 тыс. участников из регионов России и СНГ, а также очный тур, в котором приняли участие более 3 тыс. участников.
В этом году впервые приемная комиссия начисляет дополнительные 5 баллов победителям олимпиад и 3 балла призерам. Это значительно поднимает ребят в рейтинге абитуриентов. Поэтому в этом году поток участников был очень большой. В ходе организации сегодняшнего мероприятия было принято решение погрузить 11-классников в атмосферу КФУ, так как им предстоит нелегкий выбор – в какой вуз подать документы для поступления. Победителями и призерами предметных олимпиад стали более 400 одиннадцатиклассников».
В ходе слета состоялась квест-игра «Знакомство с университетом». В малом зале «Уникса» подвели итоги, состоялось награждение победителей и призеров квеста, которым вручили дипломы и сертификаты участника.
В этот же день ребята разделились по группам и отправились в профильные институты. В Институте фундаментальной медицины и биологии КФУ состоялась встречас руководством института и профессорско-преподавательским составом, вручение сертификатов победителей и призеров межрегиональных олимпиад КФУ и экскурсия по центру симуляционного и имитационного обучения ИФМиБ. Кроме того, студенты-медики ИФМиБ КФУ представили школьникам презентацию о своей стажировке в Японию, которая состоялась в феврале 2018 года.